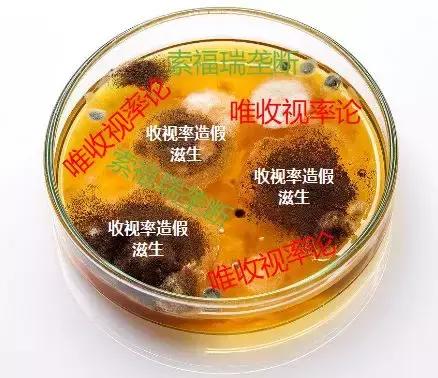
揭秘比毒品还盈利的茅台镇原浆酒,堪比毒品的暴利行业

中国电视剧的黄金年代,全民观剧是最主要的娱乐方式,经典好剧层出不穷。这些剧的收视率非常高,口碑也非常好。

不知道从何时开始,韩剧、日剧、美剧甚至是英剧风头更盛,国产剧渐渐的不那么受欢迎了,行业的怪相也开始越来越多:抠图演绎法,面瘫式表演,便宜的特效,实力演员往往担任配角。。。观众们不禁要问:电视剧行业到底怎么了?

近日,导演郭靖宇公开发博揭露电视剧行业收视率造假,宣称新作《娘道》播出前曾被某卫视要求购买收视率否则不予播出。郭靖宇称自己没有妥协。他呼吁整个影视行业团结在一起,彻底清除假收视率毒瘤。

通过沃德社会气象台的实时数据分析,小编看到,短短几天内,全网有关收视率造假的信息共有12302条。收视率造假受到各界广泛关注。国家广播电视总局、中国电视剧制作产业协会、中国电影导演协会、中国电影文学协会、首都广播电视节目制作业协会纷纷表示收视率造假应遭到严惩。陈思诚、王长田、白一骢、陆川等众多业内人士均声援表示支持对收视率造假宣战。

沃德社会气象台的情绪分析显示,针对收视率造假,全网悲伤情绪占比52.9%,愤怒情绪达到10.11%,可谓悲愤交加。
收视率造假如此可恶,产生它的温床是什么呢?收视率造假又是如何实现的?造假是谁,利益有多大?收视率造假带来怎样的危害?面对电视剧造假,以后该怎么办?小编将一一为您解答。
索福瑞的垄断和唯收视率论,成了造假的温床
电视收视率,指某一时段内收看某电视频道(或某电视节目)的人数(或家户数)占电视观众总人数(或家户数)的百分比。收视率作为“注意力经济”时代的重要量化指标,是深入分析电视收视市场的科学基础,是节目制作、编排及调整的重要参考,是节目评估的主要指标,是制定与评估媒介计划、提高广告投放效益的有力工具。
但现在收视率造假、收视率与口碑不符、为博收视率制作低俗节目等情况使收视率从一个“好东西”变成了“万恶之源。” 其实可怕的不是收视率,而是“唯收视率论”——这种单一的评价体系。
另外,在收视率统计行业,索福瑞一家独大的现状从未改变过。1996年前后,合资公司索福瑞与外资巨头尼尔森先后推出收视调查服务。但尼尔森最多也只能占据20%的市场。2008年底,尼尔森退出了中国市场,索福瑞一家独大。尽管近年来也有酷云EYE、歌华有线等新产品入市,但目前为止仍然无法撼动索福瑞的垄断地位。2014年出台的电视收视率调查国家标准中曾要求“收视率调查机构接受独立的第三方审核”,但由谁来审核、由谁出钱,一直没有下文。收视率统计一家独大的行业垄断局面,也方便了造假者的操作。
一个统计机构、一个数字维度,这样单一的评价模式,成为收视率造假的温床。
一场场对赌,衍生出假收视率的购买需求
一直以来,收视率服务的不是观众,而是各类想要在电视台投放广告的广告商。收视率数据可以告诉他们产品目标受众在哪个时间段或哪个节目聚集得更多,若是将广告投放在此处预期效果会怎样。
早期广告投放渠道单一,电视广告效果独占鳌头。电视台话语权占上风,收视率即便有造假也是零星几个,不成气候。
但后来随着广告投放渠道多元化(电视、楼宇、电梯、网站......)、制播分离(节目的生产制作与节目的播出分别由不同的单位负责的管理制度)模式的普及、“一剧双星”(一部电视剧最多只能同时在两家上星频道播出)政策的实行,让电视台的地位下降,广告商开始强势。他们非常重视收视率,这一区域商品销售情况的重要指标。
当电视广告不再是广告商唯一且最佳选择,他会对播出效果要求更高。为了避免买了某个时段广告没人看,他们会与电视台签订相关协议,收视率达到某个标准,才结算费用。对电视台来说,每日的运维成本以及购片费用已经不堪重负。广告商成了主要经济来源,为了顺利拿到广告费,维持机构的正常运转,只能完成它们的要求。

“先上车,后视情况补票”的对赌协议(制作方须向电视台担保,节目播出时可以达到一定的收视率,否则电视台会按照一定比例扣除购片款)愈加普遍。制作方就成了最后承接压力者。电视剧要想播出,就必须达到收视率标准,这样才能从电视台手中拿走购片费,达不到就只能买了,买不起就不能播了。
假收视率造售:简单粗暴利润高、现金交易
收视率造假方法有三:“污染样本户”“*听窃**和截留数据”“直接篡改数据”。第二种经索福瑞的技术改进已被清除,“直接篡改数据”至今未得到案例支持,而最低级的是“污染样本户”,但它成本最低,最容易也是唯一可能在用户层面实现的。“污染样本户”成为了收视率造假的主要手段。
那么这种造假手段的流程是什么样的呢?先雇人跟踪到样本家庭,然后*听窃**到样本家庭的私人信息,最后掏钱让样本家庭看购买收视率的作品,这就完成了一整个“污染收视率”的链条。

这是一笔简单、高效,粗暴,甚至毫无技术含量的买卖。由于样本家庭数量极小,所以干扰收视率的操作非常简单。有数据显示,2006年索福瑞在西安只有300户样本家庭,只要干扰到其中10户,就能影响当地3%的收视率。换而言之,需要一部戏在西安当地的收视率达到1%,那么只要操纵三个样本户就可以了。数据显示,40块钱,就能买到一集电视剧的“有效收视”。所以,还是以西安为例,120元,就能买到当地1%的收视率。

在过去十年,购买一集电视剧的收视率的价码,已经涨到了50万。郭靖宇的新剧《娘道》被播出平台要求购买收视率,且价格高达90万/集,全集算下来要花7200万。成本几十块,价格几十万,收视率造假每集的利润是几十万元。
据业内人士透露,有收视率造假资源的人,大部分不愿意亲自露面,因为他们要藏在后面。这样一个信息极为不透明的市场,那就产生一个可能性,到了一些竞争激烈的档期,比如说开年大戏、暑期这种时候,片方被逼在这个档期上线,又被电视台说必须要对赌收视,这个时候片方就只能找一个要么朋友介绍,要么之前用过的资源方。

这个市场属于特殊交易,特点是先拿钱,而且都是收现金的。买收视率的片方并不知道对方是谁,这种资源方卷着钱走,也时有发生。被骗的片方也不会选择报警。知法犯法,报警的同时也把自己告了。

成本几十块,价格几十万,利润高。现金匿名交易,查处困难。每年产出的电视剧达几百部,每部几十集,整个收视率造假的产值惊人。收视率造假慢慢成为了业内公开的秘密、巨大的毒瘤。
谁都不会赢的怪局面——收视率造假危害巨大
崔永元说过“收视率是万恶之源”。

收视率造假让整个演员行业变得光怪陆离,越来越不公平。收视率虚高激化了对流量演员的需求,这些演技平平甚至拙劣、时常在剧组缺席、到处出席各种商业代言活动的流量明星非常火。而追求艺德和演技的众多实力派演员、老戏骨沦为帮忙抬轿,变成点缀的绿叶。他们的演技更高,收入却更低,转行的人会越来越多。
收视率攀比对制片界的负面效应更正在日益凸显。不少从业者将收视率作为唯一目标,不仅扭曲了创作和宣传出新,为了吸引眼球而低俗炒作,制片方公司还失去了内容之道制作的评判依据,劣币驱逐良币现象日趋抬头,大量优质作品因为缺乏综合客观的评价体系而被埋没。
观众在选择电视剧时得不到有效的参考目标,只能凭运气盲目选择,浪费了时间,却看不到好的作品,观众自然对国产剧越来越失望。
广告主也无法对营销投放的效果做出合理评估,投放成本不断增加,产品和服务的价格也会水涨船高,最终导致消费者满意度下降,广告主利益受损。

广告商损失利益,制作方被裹挟,电视台丧失公信力,“唯收视率论”带来的虚假收视率造就了国产电视剧的一片虚假繁荣,使不少国产电视剧的投入重心由前期制作转向后期购买收视率,行业的法外不当竞争也导致电视作品良莠不齐,最终造成电视观众流失,重伤中国电视剧产业,整个行业健康可持续成长的土壤遭到破坏。
黑暗的尽头应是光明,新的声音开始出现
此次郭靖宇向收视率造假宣战,受到了众多圈内人的支持站台。越来越多的真相被解开,越来越多的新声音被听到。

拔出收视率造假的毒瘤,必须从购销环节出发。从市场角度,可以借鉴电影分账模式,以广告收入为标准,播出方、发行方与制作方,按一定比例分账,不再“唯收视率论”。从产业角度,首先制作方要生产优质电视剧,其次要建立公开透明的电视剧采购系统。 强化节目成本、受众和美誉度标准,吸引优质电视剧向平台聚集,使广告投放者对平台的选择更科学、合理、规范,进而淡化对收视率的依赖。
收视率调查的供给不应是索福瑞一家独大,还应有更多公司加入供大家选择。国内目前就有有线电视机顶盒能做到收视数据实时采集。类似的公司应当给予扶持。

中央电视台提出过“绿色收视率”的理念,主张“通过收视率、观众满意度、专家意见、社会效果等角度进行多方位、多层次的节目或媒体评估”,国家新闻出版*电总广局**也多次提到了这种多元化的评价体系。如何让这些多元化的评价体系落地,非常重要。目前我国AI智能技术方兴未艾,随着AI智能测算的发展,多元化评价体系技术层面的问题,相信可以逐步被解决。
郭靖宇这次向收视率造假的宣战能被听到,除了他的声嘶力竭,更因为整个行业长期以来都在翘首期盼问题的解决。黑暗的尽头是光明,希望这次郭靖宇没有白忙活一场。